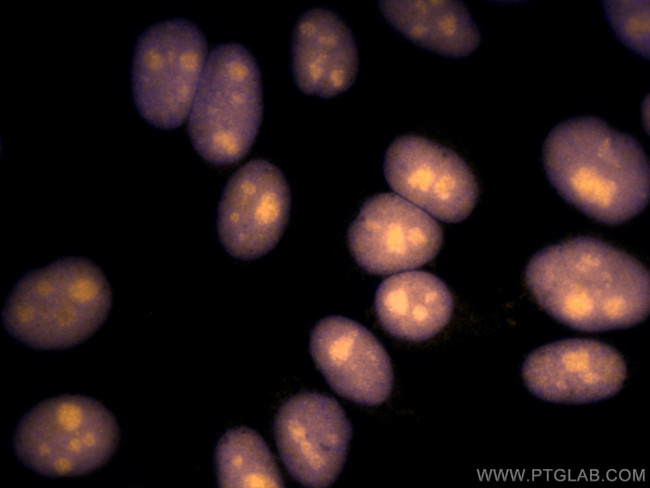
SSRP1 Antibody in Immunocytochemistry (ICC/IF)
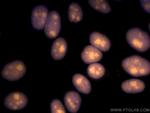
SSRP1 Antibody in Immunocytochemistry (ICC/IF)

Search
Proteintech
SSRP1 Monoclonal Antibody (3D3H4), CoraLite® 555
{{$productOrderCtrl.translations['antibody.pdp.commerceCard.promotion.promotions']}}
{{$productOrderCtrl.translations['antibody.pdp.commerceCard.promotion.viewpromo']}}
{{$productOrderCtrl.translations['antibody.pdp.commerceCard.promotion.promocode']}}: {{promo.promoCode}} {{promo.promoTitle}} {{promo.promoDescription}}. {{$productOrderCtrl.translations['antibody.pdp.commerceCard.promotion.learnmore']}}
产品信息
CL55567313100UL
种属反应
宿主/亚型
分类
类型
克隆号
偶联物
激发/发射光谱
形式
浓度
规格
纯化类型
保存液
内含物
保存条件
运输条件
靶标信息
SPT16 and SSRP1 are found in all eurkaryotic cells and exists as part of an essential heterodimer complex. Together, SPT 16 and SSRP1 are a highly abundant nuclear complex that in mammals has been called FACT, or Facilitates Chromatin Transcription. FACT enhances the processivity of RNA polymerase II through nucleosomes. Evidence also points to a role for FACT in replication, possibly by enhancing DNA polymerase through nucleosomes as well.
仅用于科研。不用于诊断过程。未经明确授权不得转售。
篇参考文献 (0)
生物信息学
蛋白别名: Chromatin-specific transcription elongation factor 80 kDa subunit; cisplatin-DNA SSRP; facilitates chromatin remodeling 80 kDa subunit; Facilitates chromatin transcription complex 80 kDa subunit; Facilitates chromatin transcription complex subunit SSRP1; FACT 80 kDa subunit; FACT complex subunit SSRP1; FACTp80; high mobility group box; hSSRP1; Recombination signal sequence recognition protein 1; Structure-specific recognition protein 1; T160
基因别名: C81323; Ciidbp; FACT; FACT80; Hmg1-rs1; Hmgi-rs3; Hmgox; SSRP1; T160
UniProt ID: (Human) Q08945, (Rat) Q04931, (Mouse) Q08943
Entrez Gene ID: (Human) 6749, (Rat) 81785, (Mouse) 20833